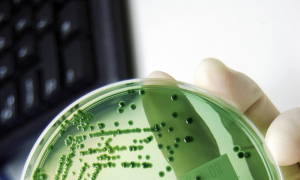

Sciences Ouest
N° 424
N° 424
Édito
Bonnes fêtes !
L’arrivée du numérique dans notre quotidien a révolutionné toutes nos pratiques et relations sociales. Cette technologie s’est développée à une vitesse fulgurante et est aujourd’hui indispensable. Retour en coulisses : Comment ça marche ? Quels sont ses avantages et inconvénients ? Les scientifiques bretons nous répondent. Nous retiendrons que ce qui peut être nocif, ce sont nos usages.
Au sommaire également, le travail d’un historien qui enquête sur la rade de Brest et le récit d’une expédition scientifique menée par des jeunes au Groenland. Une école hors du commun !
Ce numéro est le dernier de 2024. Au nom de toute l’équipe, je vous souhaite de bonnes fêtes de fin d’année.

Abonnez-vous à la newsletter
du magazine Sciences Ouest
du magazine Sciences Ouest